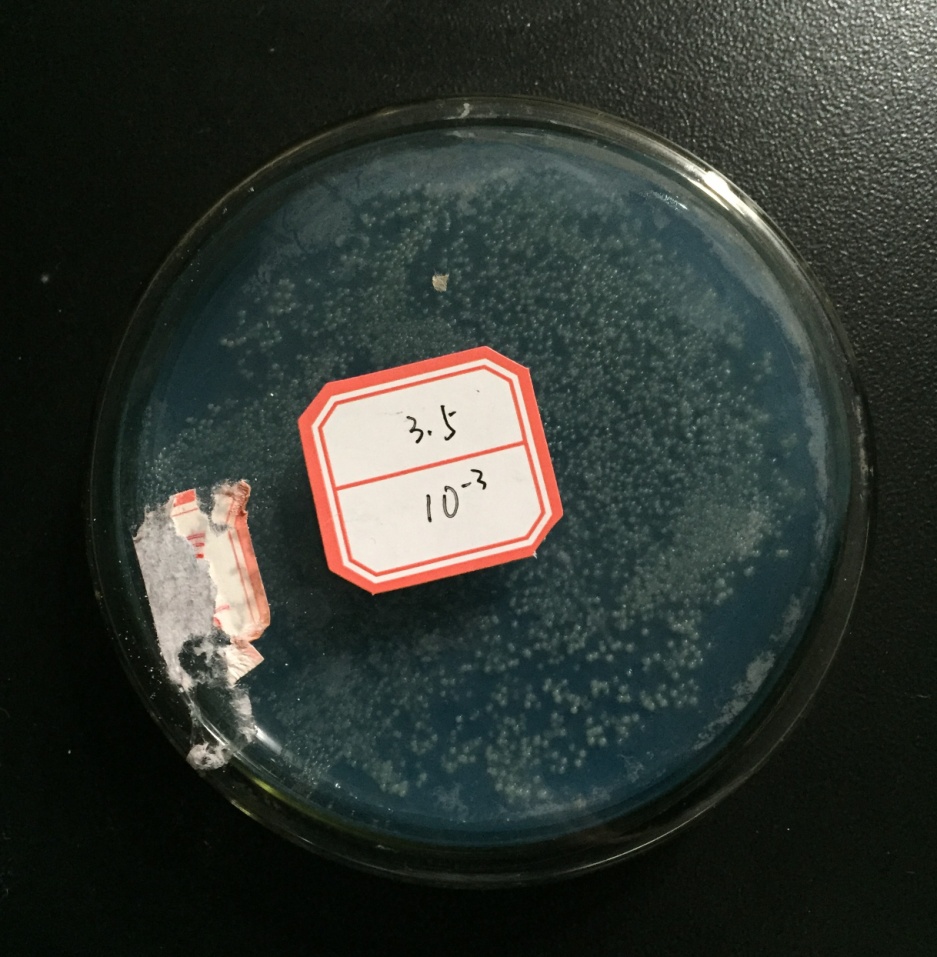
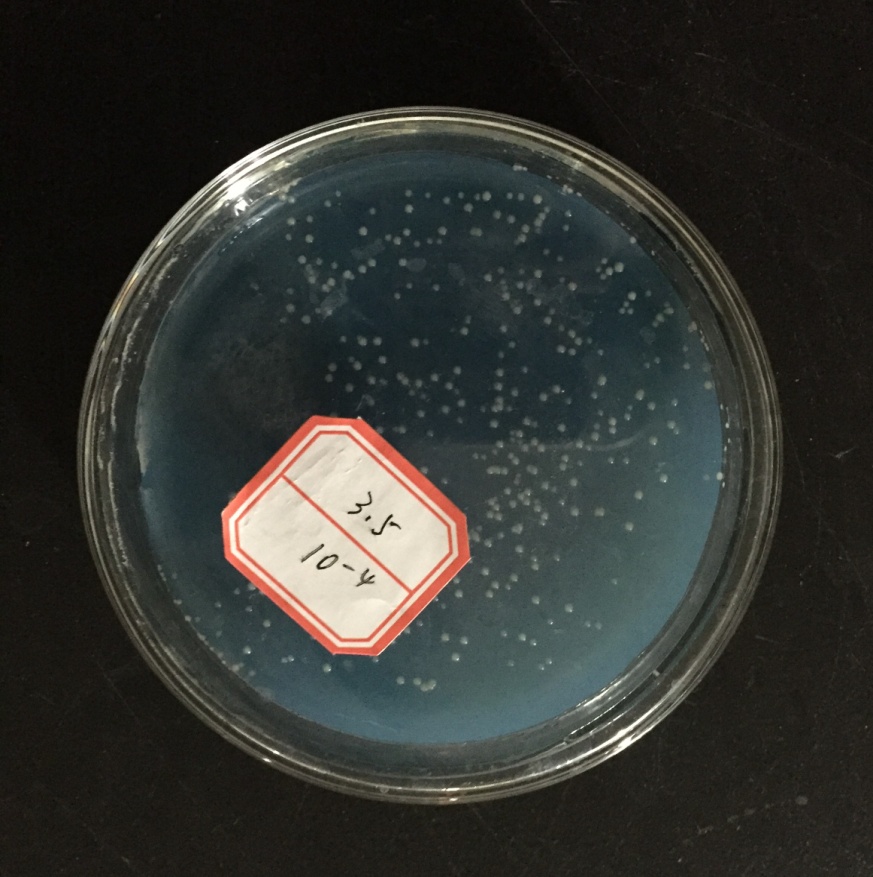
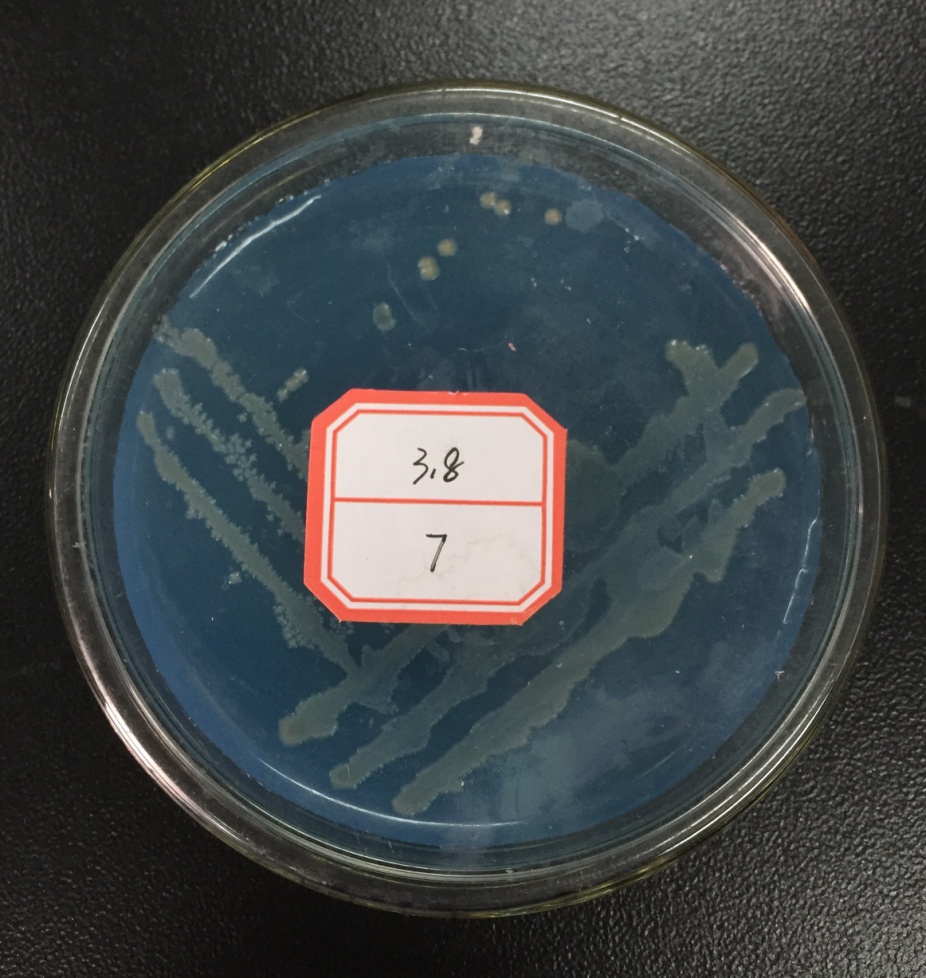
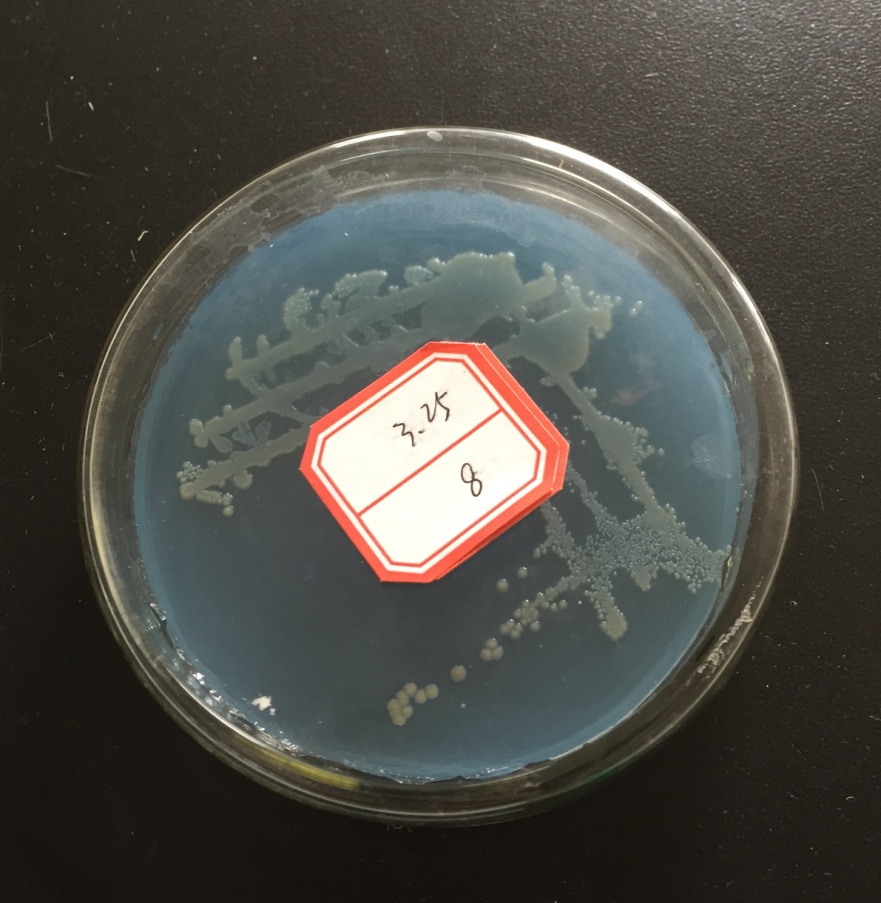

脱氮除磷颗粒污泥中反硝化微生物性能分析毕业论文
2020-02-17 09:00:16
摘 要
近年来,工业废水的大规模排放以及化肥在农业中的大规模应用,导致氮污染问题日益严重,加大对污水中氮污染的治理,尤其是提高硝酸盐氮的处理效率是目前污水处理技术中亟待解决的问题。传统的生物脱氮的过程通常涉及好氧硝化和缺氧反硝化,并且由于两个过程所需的O2含量、最佳温度、pH等条件不同,在操作时会比较复杂。好氧反硝化细菌的发现使得硝化和反硝化可以在同一容器内发生,省去了很多操作步骤。本研究从武汉理工大学实验室的SBR反应器中取样,经过富集、分离、纯化,挑选出两株脱氮效果较好的好氧反硝化细菌Y8和Y9,对其进行生化鉴定和16S rDNA同源性序列分析,并探索不同培养条件对其好氧反硝化作用的影响。
经过16SrDNA测序,确定菌株Y8和Y9为盐单胞菌属(Halomonas)。通过控制变量法探究了碳源和pH对菌株Y8反硝化作用的影响,得出结论:菌株Y8好氧反硝化的最好碳源为丁二酸钠,最适pH为6.5。
关键词:盐单胞菌;好氧反硝化;脱氮性能
Abstract
In recent years, large-scale discharge of industrial wastewater and large-scale application of chemical fertilizers in agriculture have led to an increasingly serious problem of nitrogen pollution, increasing the treatment of nitrogen pollution in sewage, especially improving the treatment efficiency of nitrate nitrogen. The traditional biological nitrogen removal process usually includes aerobic nitrification and anaerobic denitrification processes, and the denitrification process is complicated due to the different environmental conditions required for the two processes. The discovery of aerobic denitrifying bacteria allows nitrification and denitrification to occur in the same reactor, making operation easier. In this study, samples were taken from the SBR reactor of Wuhan University of Technology Laboratory. After enrichment, separation and purification, two aerobic denitrifying bacteria Y8 and Y9 with better denitrification effect were screened for biochemical identification and 16S rDNA. Homology sequence analysis and the effects of different culture conditions on aerobic denitrification.
After DNA sequencing, strains Y8 and Y9 were identified as Halomonas. The effect of carbon source and pH on the denitrification of strain Y8 was investigated by controlled variable method. It was concluded that the optimum carbon source for aerobic denitrification of strain Y8 was sodium succinate, and the optimum pH was 6.5.
Key words: Halomonas; aerobic denitrification; denitrification capability
目 录
第一章 绪论 1
1.1我国氮污染现状 1
1.2氮污染来源及危害 1
1.2.1氮污染来源 1
1.2.2氮污染的危害 2
1.3物理化学方法脱氮 3
1.3.1吹脱法 3
1.3.2折点加氯法 3
1.3.3离子交换法 4
1.3.4化学沉淀法 5
1.4生物脱氮法 6
1.4.1生物脱氮原理 6
1.4.2传统生物脱氮工艺 6
1.4.3新型生物脱氮工艺 11
1.5好氧反硝化作用机理探讨 15
1.5.1 微环境理论 15
1.5.2生物化学机理 15
1.5.3微生物理论 15
1.6好氧反硝化与传统反硝化对比 16
1.7好氧反硝化研究现状 16
1.8研究内容 16
1.9技术路线 17
第二章 材料与方法 18
2.1实验材料 18
2. 1.1菌种来源 18
2. 1.2培养基 18
2. 1.3主要仪器设备 18
2. 2实验方法 19
2.2.1分离与筛选 19
2.2.2硝酸盐氮的测定 19
2.2.3亚硝酸盐氮的测定 20
2.2.4 16SrDNA测序 21
2.2.5不同培养条件对脱氮率的影响 22
2.2.6细菌生长曲线的测定 22
第三章 结果与分析 23
3.1好氧反硝化细菌初筛结果 23
3.2菌株反硝化性能测定 27
3. 3菌株的16SrDNA测序 29
3.4不同条件对菌株脱氮性能的影响 33
3.4.1不同碳源对菌株脱氮性能的影响 33
3.4.2不同pH对菌株脱氮性能的影响 34
3.5菌株的生长曲线 35
第四章 讨论 37
4.1好氧反硝化细菌的筛选 37
4.2菌株反硝化性能测定 37
4.3菌株的16SrDNA测序 37
4.4影响反硝化作用的因素 38
4.5菌株脱氮效果及应用前景 38
参考文献 39
致谢 42
绪论
1.1我国氮污染现状
大气中的氮经过微生物的作用,或是在雷电条件下发生化学反应,然后被泥土中的各种动植物所利用,最终又通过微生物的呼吸和同化回到大气层,这就是氮循环。通常情况下,自然界中的氮元素含量可以维持动态平衡,但随着人类科技的发展和人类改造自然能力的提升,使得地球上的部分元素形态循环被破坏,人类从空气中固定下来的氮超过了大自然本身固氮的总量,氮污染亟待解决。
中国的河流和湖泊以及近海水域都遭受了不同程度的氮污染,监测显示,我国的七大河流系统中,有大约40%的流段无法满足饮用水源的标准,城市河流中78%的流域无法作为喝的和做饭用的水, 一半的地下水被污染。从1960年到2000年对黄河流域312个监测点氮含量的连续监测表明,自1990年以来水中氮含量呈持续增长状态。
太湖富营养化面积大约四分之三,夏季富营养或重度富营养占全湖面积10%左右。我国已有约20万km2的近海海域受到氮污染影响, 2000年共发生28次红潮,面积累计超过1万km2 。
1.2氮污染来源及危害
氮作为自然界物质循环中一种重要的组成元素,与我们的生活休戚相关。氮污染是由氮的化合物引发的污染,近年来因为大量使用煤、石油和天然气等燃料和含有氮元素的化肥,导致全球氮污染严重,我国人均水资源极度匮乏,氮污染已经迫在眉睫,因此研究氮污染十分重要。
1.2.1氮污染来源
随着城市化进程推进,城市大量依靠外来氮素,大自然本身的氮平衡被打破,人类活动是氮污染的重要源头。
(1)生活污水:即居民在日常生活中的排水,如清洗衣物和蔬菜、清洗身体、刷马桶等活动中产生的污水。垃圾以及某些肥皂和洗涤剂含有氮和磷,食物残渣中的有机物在细菌活动下生成氨氮,大部分生活污水在排入下水道之前都未进行脱氮除磷处理,可能导致氮污染。
(2)农业污水:指农作物种植、牲口养殖、农产品加工等活动中产生的污水,包含乡村生活污水、禽兽牲畜饲养废水和耕地水流等。耕地水流中的氮元素主要来自于未被植物和微生物固定的氮肥,我国氮肥的平均利用率为35%左右,远远低于美国等发达国家。当肥料以硝酸盐氮和亚硝酸盐氮的形式存在时,尤其容易被径流带走。农场中动物粪尿的排放量很大,废水未经消毒处理,容易使土壤受到污染。粪便随雨水流入河塘沟,将影响饮用水源的水质。据农业部统计,中国每年动物制成的食品产量将近1.5亿吨,畜禽排泄物将近40亿吨,其中只有60%能被有效处理和利用。对于靠近河岸的农场和冬天地面冻住的情况,这种污水对周围的水生和陆地生态系统产生了更大的影响。
(3)工业废水:指工业生产中的污废水及冷却水,来自化肥制造、金属冶炼、食品加工、电子产品和核燃料生产的工业废水中含有高浓度的硝酸盐和亚硝酸盐。虽然一般工业废水处理厂都设置了生物池来处理废水,但是不同于生活污水,工业废水成分复杂,并不适合微生物生长繁衍,处理难度较大。发电,工业,运输和农业大量使用化石燃料,也增加了空气中的氮含量。
1.2.2氮污染的危害
水中过量的氮元素会引起富营养化,迫害水生动植物的正常生长。氮为藻类提供了充足的养料,使其飞速增长,溶解氧浓度降低。因为O2供应不足,水中动植物纷纷死亡,从而水变成“死水”。部分藻类所含的有毒物质可以经过食物链积累,最终残留在人体内,引发各种疾病。
泥土中的固氮微生物可将单质氮转变为氨、硝酸盐等氮的化合物,提供植物的养分。但氨或铵盐过多时,反而会迫害土壤性质。此外,土壤中的硝酸盐可经反硝化作用生成N2O,N2O进入大气时会与臭氧发生化学反应而消耗臭氧层中的臭氧,引起臭氧层破坏。雨、雪吸收大气中的NO2会生成HNO3,形成pH低于5.6的酸性降水,或者以硝酸盐灰尘的形态降落,导致土壤荒芜。
水源和饮用水中氮含量太高,对人体和水体水生生物都有严重的毒害。例如,亚硝酸盐氮可以将正常的血红蛋白中的亚铁氧化成三价铁,使其失去运输氧气的功能。如果水中的氨氮超过1毫克/升,血液中血红蛋白与氧气结合的能力就会受到影响。亚硝酸盐还能与蛋白质产物反应形成亚硝胺,亚硝胺能诱发癌症。血液中结构发生改变的血红蛋白含量过高时,会导致细胞结构破坏和功能受损,危害人体健康。
如果源水中存在氨氮,则在给水处理中添加的氯量和其他消毒副产物也将极大增加,对人体健康造成威胁。
1.3物理化学方法脱氮
1.3.1吹脱法
吹脱法的基本原理是组分在气液相中的逸度相等和速率理论,将溶解在水中的氨分子转移到流动的空气层中。吹脱法通常采用充满空气和水的填充塔,污水被泵到塔的上端,并通过分配器平均地淋在填料上,水珠通过引力沿填料外边在薄膜层中往下流动,空气吹入塔底,向上流动与水接触。填料为传质提供了非常大的表面积,常用的填料为聚丙烯,这种材质具有成本低,化学惰性,重量轻,强度高的优点。在塔顶,挥发性的氨气从水转移到空气中并脱除。
提高吹脱法脱氨效率的方法有:增大污水的pH值,使平衡向右移动,促进NH4 的转化;增大气水接触面积。脱氨塔的一个普遍问题是填料的堵塞,堵塞可能发生在某些铁含量和硬度较高的废水中。溶解的铁可以在塔中被氧化,形成沉淀附着在填料上。在汽提过程中,二氧化碳也可以从水中汽提出来,从而导致pH值增大。如果废水含有较高的硬度,钙和镁将以氢氧化物的形式沉淀。对于高硬度废水,在进入汽提塔之前需要预处理降低硬度,可采用石灰软化法。使用过锰酸盐预氧化后澄清分离,可消除废水里的铁。
吹脱法的适用范围是含量高,流量大的氨氮废水。它具有容易操作,保养花费低,适应能力强,氨氮去除率高等特点,且氨气可以有效回收。该方法存在的缺点是:废水的温度会产生较大影响,低温时去除效果不佳,反应时间长,出水氨氮浓度高,影响操作过程的稳定性,可能引起二次污染,容器容易结垢等。
1.3.2折点加氯法
折点加氯法基本原理是,采用含氯氧化剂,将污水中的NH3氧化为氮气,从而将氮元素去除。当水中氯气含量达到某一点时,此时游离氯含量为最小值,氨的浓度降至零,当氯气的通入超过这一点时,水中的游离氯增加,因此该点被称为折点。如图1所示:

图1 折点加氯曲线
当Cl/N比大于7.6时,会产生游离氯;当Cl/N比小于 7.6时,除氨效果不佳。实验发现,折点加氯法的生成物大部分为N2,NCl3和硝酸盐氮很少,不存在N2O、NO2和NO。反应式如下:
NH4 HClO→NH2Cl H H2O
NH2Cl HClO→NHCl2 H2O
NHCl2 HClO→NCl3 H2O
2NH2Cl HClO→N 2↑ H 2O 3HCl
折点加氯法方法最显著的优点是可以适当控制氯含量,使流速均匀化,使废水中的氨氮减少到零,并对废水进行消毒。该法见效快,无视温度影响,投资成本低。缺点是必要投加很多的氯,药品本钱高,副产物会引发二次污染。
1.3.3离子交换法
离子交换法是使废水通过柱状压力容器, 铵离子被吸附,同时形成自由态H2S,使氨氮从水中分离。常用的吸附剂有沸石、蒙脱石、火花煤、活性炭、树脂吸附剂等。硅铝酸盐矿物沸石的构造含有大量孔隙,且能充分吸收氨氮,因而常作为交换颗粒使用。
离子交换法的一般处理方法是首先通过预处理去除废水中的漂浮固体和BOD,然后让废水流过交换容器。当交换柱饱和时,需要用无机酸修复。常用的交换体系有:
(1)固定床
在该系统中,氨氮的去除是两阶段分批过程。当交换容量全部消耗后,树脂可原地再生,通常使用下流再生方法。该方法操作简单,但反应速率较低,反应器体积较大,树脂消耗较大,有时为了适应连续流动的要求,还需要一个存储设备,因此投资成本更高。
(2)混合床
该系统将阴离子与阳离子树脂充分混合,因此树脂再生过程较为复杂,需要将两种树脂分离后进行再生。由于两种树脂比重不同,可通过液压反冲洗来分开。虽然混合床具有更快的反应速率,但它需要大量的洗涤水。另外,当收集交换的离子作为再循环产物时,回收的液体浓度较低,需要将其浓缩。
(3)移动床
反应过程分为两个阶段。在这两个阶段中,尽管水流是间歇性的,但其效果是连续的。首先,溶液和阳离子树脂沿相反方向流动,阳离子树脂经由容器波动,一端通入全新树脂,另一端排除使用完的树脂,完成离子互换和树脂修复。
与其他方法相比,离子交换法工艺简单,适用于处理氨氮浓度较低的废水或进行深度处理。该方法的缺点是离子交换树脂消耗多并且需要不断修复,在交换前还要用其他方法除去漂浮杂质。离子交换法不能完全除去氨,再生液还需要继续加工。
1.3.4化学沉淀法
化学沉淀法是在废水中,投加镁盐和磷酸盐,使之与废水中的NH4 生成难溶复盐磷酸铵镁MgNH 4PO4·6H2O (简称MAP ),通过沉淀作用使MAP从废水中分离,从而去除氨氮。反应式可表示为
Mg2 NH4 PO43-→MgNH4PO4
Haiming Huang等以磷酸作为磷源,MgO作为镁源,在n(Mg):n(N):n(P)=3:1:1的条件下处理垃圾渗滤液中的氨氮,氨氮去除率高达83%,且无需添加氢氧化钠来中和磷酸。这种方法所需镁源和磷源成本低,在保证较高去除率的同时,费用较相同情况下的传统MAP法减少68%。吴彦瑜等用MAP法进一步处理垃圾渗滤液,控制pH在10左右,反应时间为30分钟,氮磷比为1.34的条件下,氨氨去除率可到达71.2%,生成的沉淀主要为磷酸铵镁,且反应后溶液中磷含量接近于零。
化学沉淀法具有容易实施,反应速率快,温度影响小的优点,反应生成的MgNH4PO4可作为土壤添加剂和施工阻燃剂,农业肥料和医药原料,具备一定的经济价值。但是反应过程中所需的试剂量很大,水体中沉淀剂的残留磷也容易引起二次污染。
1.4生物脱氮法
1.4.1生物脱氮原理
生物脱氮的流程是在好氧条件下,硝化细菌和亚硝化细菌共同合作,将NH3转化为硝酸盐氮,然后在缺氧条件下,通过反硝化细菌的反硝化作用,将硝酸盐氮还原为氮气,同时利用有机物,并由外加碳源提供能量,来实现废水脱氮。生物脱氮法适用于各种含氮废水,总脱氮率高,次生污染小,支出较少,所以在国内外广受欢迎。
1.4.2传统生物脱氮工艺
(1)硝化作用
传统的硝化过程认为,在好氧条件下硝化菌以二氧化碳或碳酸盐为碳源,首先由亚硝化菌将氨氧化为亚硝态氮,再由硝化菌将亚硝态氮进一步氧化为硝态氮,整个过程属耗碱过程。
亚硝化菌、硝化菌统称为硝化菌,属于自养微生物,广泛存在于泥土中,在大自然氮循环中担任非常重要的角色。这种细菌能直接利用CO2作为碳源,通过化能合成作用来获得能量。硝化反应受环境变化左右较大,为了保证其顺利进行,需要创造适合的环境条件。硝化菌最适温度为35℃。
(2)反硝化作用
以上是毕业论文大纲或资料介绍,该课题完整毕业论文、开题报告、任务书、程序设计、图纸设计等资料请添加微信获取,微信号:bysjorg。
相关图片展示: